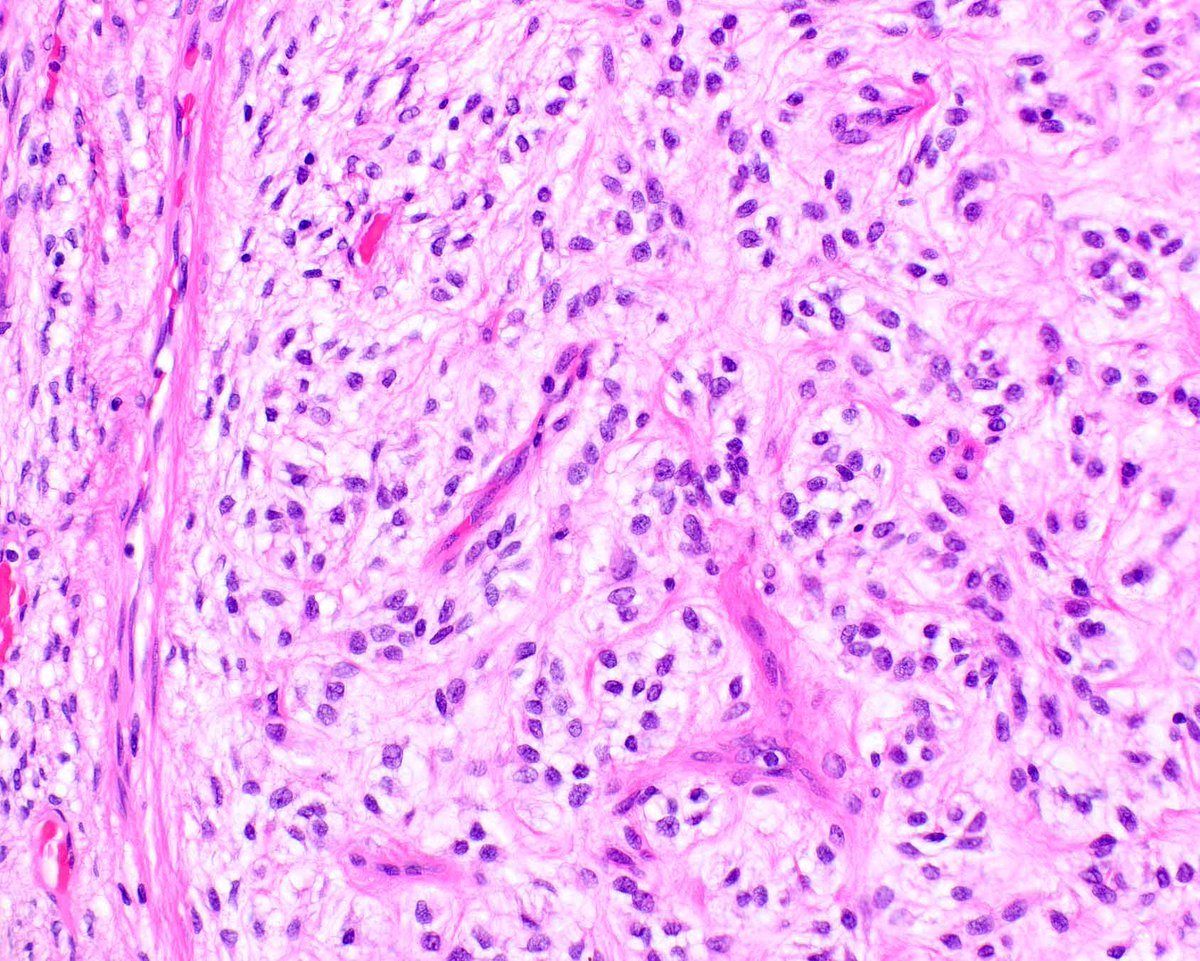
Modern Pathology tweet media
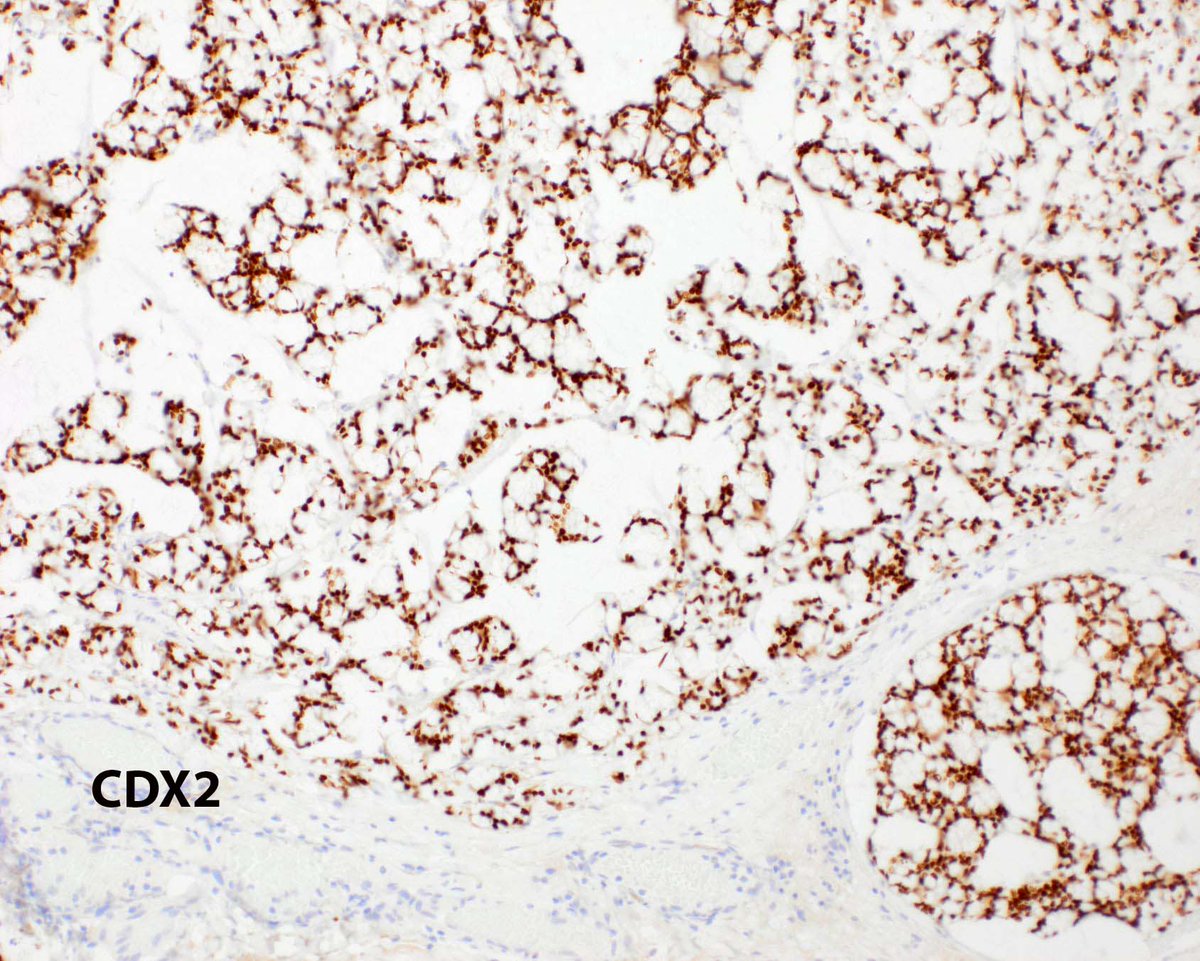
Modern Pathology tweet media
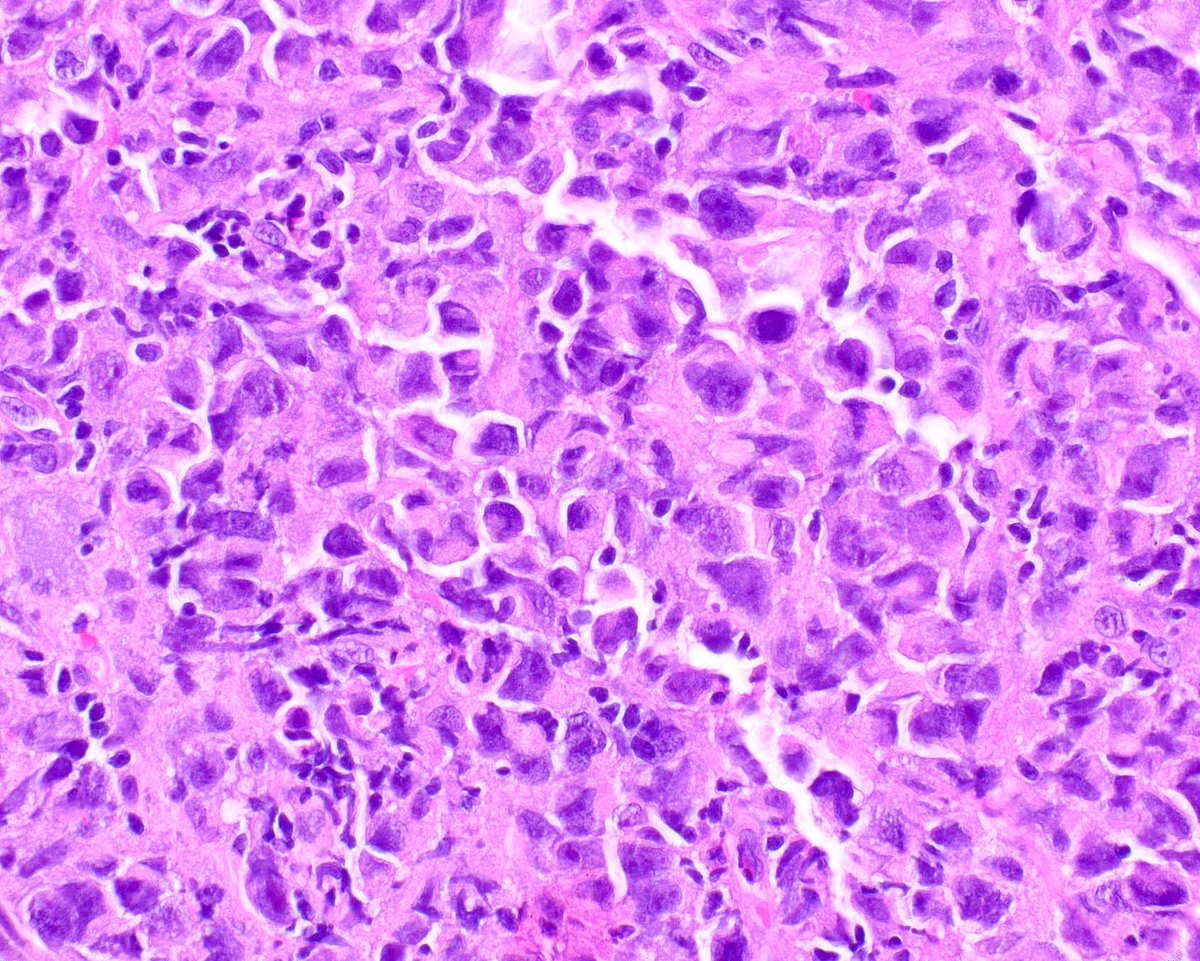
Modern Pathology tweet media
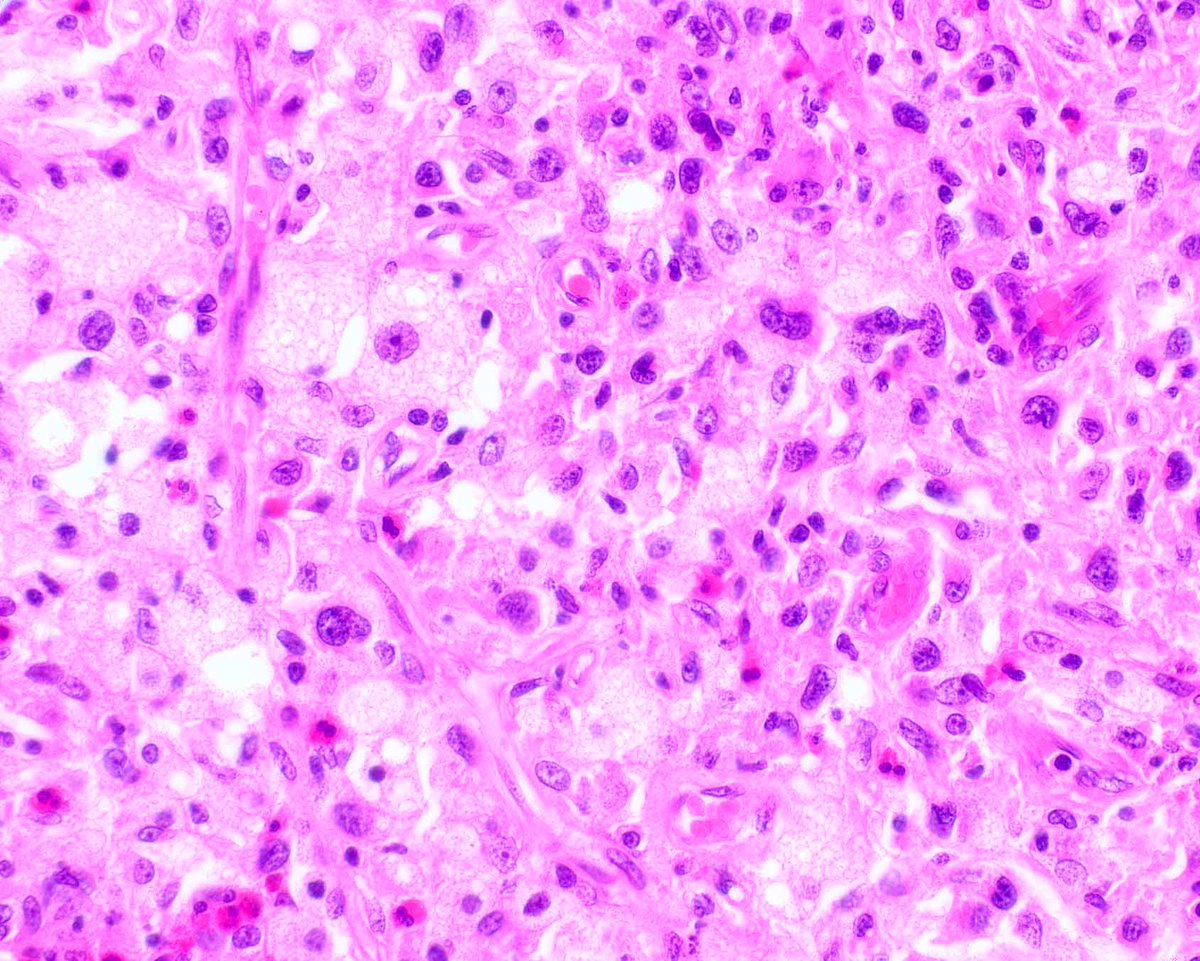
Modern Pathology tweet media

Modern Pathology
1.4K posts

Modern Pathology
@ModernPathology
Official Journal of @TheUSCAP, focused on clinical and translational research in #pathology of #humandisease. Sibling Journal: @LIjournal.

Kaposi sarcoma - note the hyaline globules (arrow). It is derived from lymphatic endothelium - confirmed a new way in Modern Pathology. Schneider JW, et al. PMID: 41478362; PMCID: PMC12860498.

This is a rather classic chordoma that has spread to the patient's lung, but there is lots more afoot! Modern Pathology helps us keep up! Sande WJ, et al. PMID: 39577663.

Although there is an association between ovarian primary mucinous tumors and Brenner tumors, in this case, a Brenner tumor has collided with metastatic pancreatic ductal adenocarcinoma. Mod Pathol. 2020 Apr;33(4):722-733. PMID: 31695154.

An interpretation of myofibroma (and some related lesions) can be confirmed by in situ hybridization for PDGFRB. Mod Pathol. 2023 Mar;36(3):100070. PMID: 36788105.

Myxoinflammatory fibroblastic sarcoma was first reported in Modern Pathology years ago using descriptive terminology by Sharon Weiss and her colleagues. Reed-Sternberg like cells (large arrows) and an eosinophil are indicated. PMID: 9578090.